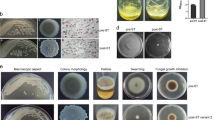

Abstract
The ability of soil bacteria to successfully compete with a range of other microbial species is crucial for their growth and survival in the nutrient-limited soil environment. In the present work, we studied the behavior and transcriptional responses of soil-inhabiting Pseudomonas fluorescens strain Pf0-1 on nutrient-poor agar to confrontation with strains of three phylogenetically different bacterial genera, that is, Bacillus, Brevundimonas and Pedobacter. Competition for nutrients was apparent as all three bacterial genera had a negative effect on the density of P. fluorescens Pf0-1; this effect was most strong during the interaction with Bacillus. Microarray-based analyses indicated strong differences in the transcriptional responses of Pf0-1 to the different competitors. There was higher similarity in the gene expression response of P. fluorescens Pf0-1 to the Gram-negative bacteria as compared with the Gram-positive strain. The Gram-negative strains did also trigger the production of an unknown broad-spectrum antibiotic in Pf0-1. More detailed analysis indicated that expression of specific Pf0-1 genes involved in signal transduction and secondary metabolite production was strongly affected by the competitors’ identity, suggesting that Pf0-1 can distinguish among different competitors and fine-tune its competitive strategies. The results presented here demonstrate that P. fluorescens Pf0-1 shows a species-specific transcriptional and metabolic response to bacterial competitors and provide new leads in the identification of specific cues in bacteria–bacteria interactions and of novel competitive strategies, antimicrobial traits and genes.
Similar content being viewed by others
Introduction
Soil microbial communities represent the world's greatest reservoir of biological diversity known so far (Curtis et al., 2002; Torsvik and Ovreas, 2002). Most known soil bacterial species are organotrophs that is, they obtain the energy for growth from the assimilation of organic compounds. However, the availability or accessibility of degradable organic compounds is limited in most soils (Alden et al., 2001; Demoling et al., 2007). In addition, there is a high degree of overlap in metabolic abilities of organotrophic bacteria (Strickland et al., 2009). This implies that a particular bacterial species is likely to encounter numerous taxonomically different competitors in different microsites in soil ecosystems.
Bacteria explore their biotic and abiotic environments by sensing and responding to a wide variety of chemical stimuli (Taga and Bassler, 2003; Ryan et al., 2008; Shank and Kolter, 2009; Straight and Kolter, 2009) possibly providing them with information on the identity of the nearest competitor(s). Indeed, recent studies revealed that bacteria alter their gene expression when confronted with another bacterial species (Garbeva and de Boer, 2009; Tai et al., 2009).
Most characterized bacterial species harbor multiple two-component signal transduction systems that enable the coupling of a diverse array of adaptive responses to neighboring macro- and microorganisms, and to abiotic environmental changes (Gao et al., 2007). Pseudomonas species, which are frequently isolated from complex environments, such as soil and rhizosphere, possess a range of two-component signal transduction proteins (for example, 212 in Pseudomonas fluorescens Pf0-1, 223 in P. fluorescens Pf-5, 179 in P. putida KT2440 and 203 in P. syringae DC3000 (http://genomics.ornl.gov/mist)), which are thought to permit rapid responses to environmental changes (Heeb and Haas, 2001; Dubuis et al., 2007; Humair et al., 2010). In these complex natural environments, Pseudomonas species coexist with many other bacterial species. We hypothesize that signal transduction systems may, in part, have a role in fine-tuning their responses towards the nearest competing microbe and to optimize their competitive behavior.
Among the genes that are upregulated during interspecific bacterial interactions are often the genes involved in the production of antibiotics, suggesting that antibiosis may be a common defensive or offensive strategy in microbial interactions (Fong et al., 2001; Harrison et al., 2008; Garbeva and de Boer, 2009). In addition, genes that confer resistance against toxins were also found to be upregulated during competitive interactions, suggesting protection against self-intoxication or against toxins produced by other members of the microbial community (Dantas et al., 2008; Martinez 2008, 2009). Whether upregulation of genes involved in this ‘chemical warfare’ improves competitive success will depend on the sensitivity of the competitor to the antibiotic(s) and the resistance of the strain of interest to the competitor's toxins. Hence, it is likely that both toxin production and resistance may need to be adapted or tailored toward the identity of the competitor. Besides toxin production and resistance, modulating expression of other genes and cellular processes may also be required to sustain a population in a dynamic, competitive environment. To date, however, no reports have documented the variation in transcriptional responses of bacteria to different competitors.
In the present work, we investigated the ability of soil-inhabiting P. fluorescens strain Pf0-1 to cope with different competitors under nutrient-poor conditions. We examined the behavior and transcriptional responses of Pf0-1 during interaction with strains of three phylogenetically different bacterial genera, that is, Bacillus, Brevundimonas and Pedobacter. The results show that P. fluorescens Pf0-1 can distinguish between different competitors. Common transcriptional responses were also identified, including upregulation of cryptic genes in Pf0-1, which we demonstrate to be important for production of an antimicrobial compound.
Materials and methods
Bacterial cultures and growing conditions
The bacterial strains used in this study are summarized in Table 1.
These include P. fluorescens Pf0-1, Pedobacter sp. V48, Brevundimonas sp. V52 and Bacillus sp. V102. P. fluorescens Pf0-1 was isolated from an agricultural loam soil in Sherborn (MA, USA), whereas the other strains were isolated from a coastal dune site in The Netherlands (Compeau et al., 1988; de Boer et al., 2003, 2007). This coastal dune soil does also contain pseudomonads that are closely related to P. fluorescens Pf0-1 (de Boer et al., 2007). The strains were pre-cultured from frozen glycerol stocks on 1/10 strength Tryptic Soy Broth agar.
The interaction experiments were performed using the carbon-limited water-agar medium (WA-N), which has been used in a previous study (Garbeva and de Boer, 2009). This medium contained 20 gl−1 of Agar, 5 gl−1 of NaCl, 1 gl−1 of KH2PO4 and 0.1 gl−1 of (NH4)2SO4. The pH was adjusted to 6.5 before autoclaving. (Garbeva and de Boer, 2009). The WA-N agar plates (8.5-cm diameter) were divided into two zones (Supplementary Information Figure S1): zone B1, harbors P. fluorescens Pf0-1; and zone B2 contains one of the competing bacteria. Zones B1 and B2 were separated 1.5 cm from each other and all strains were inoculated with equal densities. Bacterial inocula, consisting of 20 μl washed cell suspensions in a 10 mM phosphate buffer (pH 6.5) and containing 107 cells per ml, were spread in the appropriate zone. All plates were incubated at 20 °C for 5 days. On the fifth day, bacterial cells were collected for enumeration (see below), whereas P. fluorescens Pf0-1 was also collected for RNA extraction.
Enumeration of bacteria
Two agar discs (1-cm diameter) were cut from the bacterial zones on WA-N plates and shaken in 10 mM phosphate buffer (pH 6.5) for 90 min. Serial dilutions were plated on 1/10 Tryptic Soy Broth agar plates. Plates were incubated at 20 °C and colonies were counted after 48 h.
Microarray experiment, RNA isolation and cDNA synthesis
Total RNA was extracted from P. fluorescens Pf0-1 growing on WA-N plates with or without (control) the presence of competing bacteria. For total RNA extraction, the WA-N agar zone carrying P. fluorescens Pf0-1 was cut from the plate (to prevent contamination by the competing species during recovery of cells) and the cells were suspended in 1.5 ml of sterile phosphate buffer. All suspensions were diluted in sterile phosphate buffer to the same optical density (OD; 600 nm) to obtain equal amounts of cells for RNA extraction. The cells were centrifuged at 16 000 × g for 3 min. RNA was extracted from the cell pellets with the Artrum Total RNA Mini Kit (Bio-Rad, Veenendaal, The Netherlands cat No. 732-6820) according to the manufacturer's recommendations. The extracted total RNA was treated with the TURBO DNA-free Kit to remove DNA (Ambion, Nieuwerkerk a/d lJssel, The Netherlands; cat No. 1907). Before creating complementary DNA (cDNA), the RNA concentrations in the samples were quantified with a NanoDrop Spectrophotometer (Isogen Life Science, IJssestein, The Netherlands). RNA quality was verified using the Experion System (Bio-Rad).
First strand cDNA was synthesized from 10 μg total RNA with random hexamer primers from Invitrogen (Breda, The Netherlands; cat No. 48190-011) using SuperScript Double-Stranded cDNA Synthesis kits (Invitrogen cat No. 11917-010). The cDNA synthesis was carried out according to the NimbleGen protocol for synthesis of double-stranded cDNA.
Microarray design and data analysis
On the basis of the sequence and annotation data for P. fluorescens Pf0-1, high-density, multiplex (4 × 72 K) microarrays were designed and produced by Roche NimbleGen (NimbleGen Systems of Iceland, Reykjavík, Iceland; cat No. A7241-00-01). The arrays consisted of 60-mer probes covering 5735 genes, 6 probes per gene and 2 replicates. Labeling of cDNA with Cy3 dye and hybridization was performed by Roche NimbleGen.
On each 4 × 72 K format microarrays two replicate interactions and two replicate controls were performed. The lists of differential expressed genes were extracted by comparison of each interaction to the control. The Robust Microarray Analysis-normalized gene expression data were analyzed with the Array Star 2 software for microarray analysis (DNASTAR, Madison, WI, USA). Analysis was performed, with application of false discovery rate (Benjamini–Hochberg method) and multiple testing corrections.
Quantitative Real-Time PCR
Quantitative Real-Time PCR (qRT-PCR) was performed on the original RNA extracts to verify the gene expression detected by microarray analysis. First-strand cDNA was obtained as described above. A volume of 2 μl of cDNA was subjected to RT-PCR using SYBR Green PCR master mix (Applied Biosystem, Warrington, UK). For each target gene (35 differentially expressed genes and 3 control genes- non differentially expressed), forward and reverse primers (Supplementary Information Table S1) were designed using Primer Express software (PE, Applied Biosystem). All primers used for real-time PCR were first tested using conventional PCR with DNA isolated from P. fluorescens Pf0-1. Real-time PCR was performed using a Corbett Research Rotor-Gene 3000 thermal cycler (Westburg, Leusden, The Netherlands) with the following conditions: initial cycle 95 °C for 15 min and 40 cycles of: 95 °C for 15 s; 56 °C for 50 s; and 72 °C for 50 s. The incorporation of SYBR Green in double-stranded DNA allowed the determination of the threshold cycle, which identifies the moment of the PCR cycle at which PCR amplicons exceed the detection limit. Standard curves were established for each cDNA sample.
Extraction of antimicrobial compounds
The extraction of antimicrobial compound(s) was carried out according to the methods described by Raaijmakers et al. (1999). Briefly, the WA-N agar zone carrying P. fluorescens Pf0-1 was removed carefully from the plate and cut in small (1-cm diameter) pieces. These pieces were vigorously shaken in 20 ml of 80% (v/v) acetone for 1 h at room temperature. The acetone solution was centrifuged for 10 min at 4000 × g and the acetone was evaporated under air flow. The water fraction was acidified with trifluoroacetic acid (0.1% (v/v)), mixed with 2 volumes of ethylacetate and shaken vigorously for 5 min.
After incubation for overnight at −20 °C the unfrozen (ethylacetate) fraction that contains the active compounds was carefully transferred to a new flask and dried under air flow. The dried extract was dissolved in 150 μl of 50% (v/v) methanol and subjected to reverse phase high pressure liquid chromatography analysis.
Construction and use of Pf0-1 mutants
On the basis of the microarray and qRT-PCR analyses, several gene clusters were selected for site-directed mutagenesis. Genes were deleted from the P. fluorescens Pf0-1 genome by SOE-PCR (Horton et al., 1989) and allele exchange using suicide plasmid pSR47s (Matthews and Roy, 2000) as described previously (Silby and Levy, 2004). Two of the deletion mutants obtained, Pfl01_3463-66 (bases 3947327-3952129) and Pfl01_3655-59 (bases 4136447-4143889), were used for comparison of antibiotic production with the wild-type strain. Each deletion was confirmed by PCR analysis using at least one primer that anneals outside of the regions used in the allelic exchange to create the deletions.
Assay for testing antimicrobial activity of the extract
The extracts of antimicrobial compound dissolved in methanol were tested for activity against hyphal growth of the fungi Rhizoctonia solani, Fusarium culmorum, Trichoderma harzianum and Mucor hiemalis in 12-well open-chamber plates (Cat No. 665180 Greiner bio-one, Frickenhausen, Germany) with 250 μl WA-N agar in each well. Each well was inoculated on one side with 6-mm diameter agar discs containing fungal hyphae. A volume of 10 μl of the extracts were added to sterile filter paper discs (Whatman No.1, Whatman, Whatman Nederland BV, Hertogenbosch, The Netherlands; 6-mm diameter) and placed on the opposite side of the wells. The 12-well plates were inoculated for 48 h at 20 °C and checked for fungal inhibition by measuring hyphal extension. Filter paper discs containing 10 μl of 50% methanol were used as control.
The effect of the antimicrobial compound(s) on Bacillus sp. V102, Pedobacter sp. V48 and Brevundimonas sp. V52 growth was tested by mixing 5 μl of the extracts with 25 μl of bacterial cell suspensions containing 107 cells per ml and plating immediately the bacterial suspension on 1/10 Tryptic Soy Broth agar plates. The plates were incubated at 20 °C and enumeration was carried out after 72 h. As a control 5 μl of 50% methanol was added to the 25 μl bacterial cell suspensions.
Statistical analysis
For each experiment, replicates were used: two for the microarray experiments and three for all other experiments. The statistical analysis of microarray data were performed with the Array Star 2 software for microarray analysis (DNASTAR).
The statistical analyses of bacterial enumeration, antagonistic tests and qRT-PCR data were carried out with XLStat 2010 (Addinsoft, New York, NY, USA) using a two-tailed t-test, assuming unequal variance between data sets. Data were considered to be statistically different at P⩽0.05.
Results
Effect of interspecific interactions on P. fluorescens populations
The numbers of bacteria that had developed in the different zones (B1 and B2 see Supplementary Information Figure S1), on WA-N agar were estimated to confirm that competitive interactions were occurring between P. fluorescens Pf0-1 and the other strains. The density, expressed as colony forming units (CFUs), of P. fluorescens Pf0-1 in the inoculation zone B1 was significantly reduced by the presence of another bacterial species (Figure 1a). Cell density of Pf0-1 was most negatively affected by the presence of the Bacillus strain. The latter was more abundant than P. fluorescens Pf0-1 during interaction whereas numbers of P. fluorescens Pf0-1 remained higher than those of the Brevundimonas and Pedobacter strains. The CFU of Brevundimonas and Pedobacter monocultures (Figure 1b) were significantly higher than the CFU of Brevundimonas and Pedobacter during interaction with P. fluorescens Pf0-1. There was no significant difference between CFU of Bacillus monoculture and CFU of Bacillus interacting with P. fluorescens Pf0-1.
(a) Number of bacterial colony forming units (CFUs) produced during competitive interactions of Pseudomonas fluorescens Pf-01 with other bacteria on nutrient-poor agar: Pf0-1 × Pf0-1, interaction with P. fluorescens Pf0-1; Pf0-1 × PdV48, interaction with Pedobacter sp. V48; Pf0-1 × BrV52, interaction with Brevundimonas sp. V52; and Pf0-1 × Bacil, interaction with Bacillus sp. V102. Details of the experiment are given in Material and methods. Presented values are means of three replicates, error bars indicate s.d. and different letters indicate significant differences (P<0.05) in Pf0-1 CFU. (b) Number of bacterial CFUs produced by monocultures of Pf0-1, P. fluorescens Pf0-1; PdV48, Pedobacter sp. V48; BrV52, Brevundimonas sp. V52; and Bacil, Bacillus sp. V102. *Indicates significant differences in CFU between monoculture and interaction with P. fluorescens Pf0-1 (P<0.05).
Transcriptional responses of P. fluorescens Pf0-1 to other bacterial species
The response of P. fluorescens Pf0-1 to different bacterial competitors was studied by determining gene expression profiles. The presence of phylogenetically different soil bacteria in physically separated zones on nutrient-poor agar caused numerous changes in Pf0-1 gene expression (Table 2). Application of false discovery rate (Benjamini–Hochberg method) and multiple testing corrections revealed that each competing strain caused significant (P<0.05) transcriptional changes of twofold or higher; qRT-PCR analysis of 35 selected differentially expressed genes confirmed the microarray data (data not shown). The presence of Bacillus sp. caused the highest number (571) of gene expression changes. The presence of Pedobacter sp. and Brevundimonas sp. caused changes in the expression of 422 and 325 genes, respectively (see Supplementary Information Tables S2, S3 and S4 for complete lists).
We subsequently searched for common transcriptional changes in Pf0-1 in response to the presence of the three different competing bacterial species. Despite the large number of genes that were differentially expressed in each interaction, only 42 were common to all three interactions, with putative functions in energy production and conversion (eight genes), amino acid transport and metabolism (six genes), signal transduction mechanisms (six genes), inorganic ion transport and metabolism (four genes), nucleotide transport and metabolism (four genes) and cell motility and secretion (three genes) (Figure 2, Table 3).
Venn diagram representing the number of differentially expressed genes in P. fluorescens Pf0-1 during inter-specific competitive interactions. Each circle represents the number of differentially expressed genes during interspecific competitive interaction with a single strain: green circle, interaction with Pedobacter sp. V48 (total 422 genes); blue circle, interaction with Brevundimonas sp. V52 (total 325 genes); and light indigo circle, interaction with Bacillus sp. V102 (total 571 genes). Italic and bold numbers represent the common differentially expressed genes in all two and three interactions, respectively.
Comparison of the interactions of P. fluorescens Pf0-1 with Pedobacter sp. and Bacillus sp. revealed that the expression of 92 genes was affected by both bacteria (43 up- and 49 downregulated), whereas changes in 71 genes (43 up- and 28 downregulated) were common to the interaction with Brevundimonas sp. and Bacillus sp. However, the common response to the two Gram-negative bacteria was far greater (Figure 2), comprising 184 genes (87 upregulated and 97 downregulated genes; Supplementary Information Table S5).
Comparison of differentially expressed genes related to signal transduction
During interspecies interaction, expression of several genes related to two-component signal transduction systems was found to be altered compared with monoculture (Table 4), with six common to all three interactions.
The highest number of affected genes related to two-component signal transduction systems was detected during the interaction of Pf0-1 with Bacillus sp. (31 up- and 5 downregulated). The presence of Pedobacter sp. and Brevundimonas sp. altered expression of 16 and 15 genes related to two-component signal transduction systems, respectively. However, only seven of these were common for both interactions.
Differential expression of ribosomal proteins and phage-related genes
In all three interactions differential expression of genes encoding ribosomal proteins was observed. During the interactions with Pedobacter sp. and Brevundimonas sp., a nearly identical set of ribosomal protein genes showed altered expression, with similar directions (upregulation and downregulation). The interaction with Bacillus sp. led to downregulation of 13 ribosomal protein genes, of which only two were seen in other interactions (Supplementary Information Figure S2).
During the interaction with Bacillus sp., increased expression of phage-related genes was noted. In particular, expression of every gene (apart from Pfl01_1136 and 1163) in the putative prophage region Pfl01_1136 to Pfl01_1173 was elevated in the range of 2.1–8.5 with most of the expression increased by at least fourfold (all upregulated phage-related genes are indicated in bold in Supplementary Table S2 in Supplementary Information). None of these putative prophage genes was up- or downregulated during the interactions with Brevundimonas sp. and Pedobacter sp.
Interspecies interactions induce genes involved in antimicrobial compound production in P. fluorescens Pf0-1
During interaction with Pedobacter sp. and Brevundimonas sp. several genes were upregulated in Pf0-1, which may be involved in the valine, leucine and isoleucine degradation pathway. Two gene clusters within this pathway, Pfl01_3463-3466 and Pfl01_3655-59, are described in Figure 3. The gene cluster Pfl01_3463-3466 may encode for components of the branched-chain α-keto acid dehydrogenase complex. In Streptomyces avermitilis, a branched-chain α-keto acid dehydrogenase gene cluster is essential for polyketide backbone synthesis (Denoya, 1995; Yoon et al., 2004). Moreover, it was demonstrated that branched-chain amino acids can serve as precursors for Type II polyketide synthesis through pathways that are nutrient dependent (Stirrett et al., 2009). The upregulation of this gene cluster was observed only in the Pf0-1 interactions with Brevundimonas and Pedobacter, but not with Bacillus.
Graphic representation of gene clusters deleted in non-antibiotic producing mutants. (a) Pfl01_3463-3466 (Pfl01_3463 and Pfl01_3464, two branched-chain α-keto acid dehydrogenase E1 components; Pfl01_3465, branched-chain α-keto acid dehydrogenase subunit E2; and Pfl01_3466, dihydrolipoamide dehydrogenase). (b) Pfl01_3655-3659 (Pfl01_3655, AMP-binding domain protein; Pfl01_3656, isovaleryl-CoA dehydrogenase; Pfl01_3657, propionyl-CoA carboxylase; Pfl01_3658, γ-carboxygeranoyl-CoA hydratase; and Pfl01_3659, 3-methylcrotonoyl-CoA carboxylase, α subunit). In both panels, dashed lines indicate the deleted region and numbers in boxes refer to the nucleotide position in the Pf0-1 genome.
The role of upregulated branched-chain amino acid degradation genes in antimicrobial compound production
The first step to determine whether antimicrobial compounds are produced by Pf0-1 during interactions with the competing bacteria involved in organic extractions of the agar surrounding Pf0-1 when confronted with each of the three bacterial strains, followed by assays in which the antimicrobial effects of the extracts were tested. The densities of Pedobacter, Brevundimonas and Bacillus were indeed significantly reduced when exposed to the extract obtained from P. fluorescens Pf0-1 cocultured with Pedobacter relative to the extract from Pf0-1 monoculture (Figure 4a). We subsequently investigated whether the antimicrobial compound(s) produced during the interaction of Pf0-1 with Pedobacter also had activity against soil-borne saprophytic and pathogenic fungi. Activity bioassays showed that the extract inhibits mycelial growth of several fungi, including Rhizoctonia solani, Mucor hiemalis and Trichoderma harzianum (Figure 4b). No such inhibitory effect was observed for the extract produced by Pf0-1 during the interaction with Bacillus (Figure 4c).
(a) Effect of extracts from P. fluorescens Pf0-1 zones on growth of bacteria: Bacill, Bacillus sp. V102; BrV52, Brevundimonas sp. V52; and PdV48, Pedobacter sp. V48. Control, extract from P. fluorescens Pf0-1 monoculture; Antimicrobial extract, extracts from the P. fluorescens Pf0-1 zone during interaction with Pedobacter sp. V48. *Indicates significant differences within column pairs (P<0.05). (Supplementary Figure 4) (b) Effect of extracts from P. fluorescens Pf0-1 zones on growth of fungi i, Rhizoctonia solani; ii, Mucor hiemalis; iii, Trichoderma harzianum. C, control extract from P. fluorescens Pf0-1 monoculture; M, 50% methanol; and E, extracts from the P. fluorescens Pf0-1 zone during interaction with Pedobacter sp. V48. (c) Effect of extracts from P. fluorescens Pf0-1 zones on R. solani. C, control 50% Methanol; 1, extract from Pf0-1 monoculture; 2, extract from Pf0-1 interacting with Bacillus sp. V102; and 3, extract from Pf0-1 interacting with Pedobacter sp. V48.
To determine whether the upregulated genes in the Pfl01_3463-3466 and Pfl01_3655-3659 clusters are indeed involved in the production of the observed antimicrobial activity, each of the two gene clusters in Pf0-1 were deleted by site-directed mutagenesis (Table 1 and Figure 3). In contrast to the extracts obtained from wild-type strain Pf0-1 when interacting with Pedobacter, the extracts from the deletion mutants Δ3463-66 and Δ3655-59 under the same interaction conditions did not exhibit activity against R. solani (Figure 5). Subsequent analysis of these extracts by high pressure liquid chromatography showed the absence of at least three specific peaks in extracts of the mutants that were present in extracts of the wild-type strain (Supplementary Information Figure S3). High pressure liquid chromatography analysis followed by photodiode array analysis of the chromatograms (288 nm) further showed highly similar metabolite patterns for P. fluorescens Pf0-1 extracts when cocultured with Pedobacter or Brevundimonas. In contrast, the metabolite pattern of extracts obtained from P. fluorescens Pf0-1 cocultured with Bacillus was different from that of extracts obtained from Pf0-1 interacting with the other two strains (Supplementary Information Figure S3). The metabolite profiles of all extracts were also different from those obtained from the control extract, that is, extract obtained from Pf0-1 monoculture.
Antagonist assay against Rhizoctonia solani with extracts from: 1, P. fluorescens Pf0-1 monoculture; 2, P. fluorescens Pf0-1 interacting with R. solani; 3, P. fluorescens Pf0-1 interacting with Pedobacter sp.V48; 4, P. fluorescens Pf0-1 Δ3655 interacting with Pedobacter sp.V48; 5, P. fluorescens Pf0-1 Δ3463 interacting with Pedobacter sp.V48; and C, control 50% methanol.
Discussion
In soil and rhizosphere environments, Pseudomonas species coexist with many other bacterial species. Several of these species compete for the same ecological niche and nutrient resources (Demoling et al., 2007). Therefore, the ability to cope with the presence of a range of competing microbial species is essential for growth and survival in soil ecosystems. The results of this study showed that the identity of the competing bacterium is an important determinant of the behavioral and genetic response of P. fluorescens Pf0-1. The genome-wide microarray analyses revealed a specific transcriptional response of Pf0-1 to each competitor as only a small percentage of the differentially expressed genes was common to all three interactions. Both Brevundimonas and Pedobacter, but not Bacillus, induced the production of antimicrobial metabolites in P. fluorescens Pf0-1, further supporting the specific nature of the response of P. fluorescens Pf0-1 to different competitors.
Most bacteria, including Pseudomonads, possess two-component signal transduction systems that help them to adapt to fluctuating environmental conditions (Gao et al., 2007). The expression of several P. fluorescens Pf0-1 genes involved in two-component signal transduction increased during interspecific interaction. This suggests an adaptive response of P. fluorescens Pf0-1 to the presence of unrelated microorganisms. Among the two-component regulatory genes that were significantly upregulated in all three interactions was the regulatory gene Pfl01_1534. This gene is an ortholog of fleR in P. aeruginosa, which is a regulator of genes for flagella biogenesis, chemotaxis, fimbrial biogenesis, and several genes annotated as ‘hypothetical’ (Dasgupta et al., 2003). Elevated expression of this regulator may suggest that motility and/or chemotaxis are important and general components of the P. fluorescens response to other bacteria. Unlike Pfl01_1534, most of the differentially expressed ‘signal transduction genes’ were specific for a particular interaction (only six were common among the three interactions studied), suggesting that each competing bacterial species may produce specific cues that are perceived by P. fluorescens Pf0-1, triggering specific responses in addition to general ones. When comparing the transcriptional responses of P. fluorescens Pf0-1 to the presence of the different competing strains, the highest similarity was found for the two Gram-negative bacteria Brevundimonas and Pedobacter. This was the case for all genes including those related to two-component signal transduction systems. Whether the Gram-negative bacteria tested in this study exhibit a higher degree of overlap in specific cues as compared with those produced by the Gram-positive Bacillus strain remains to be tested.
The competing strains had also specific effects on Pf0-1 genes encoding ribosomal proteins. During the interaction with Brevundimonas and Pedobacter, a nearly identical set of ribosomal proteins were up- or downregulated, whereas only downregulated ribosomal proteins were found during the interaction with Bacillus (Supplementary Information Figure S2). Ribosomal proteins may have various functions apart from ribosome and protein synthesis (Wool, 1996). Downregulation of ribosomal proteins has been linked to various stress responses as well to a decrease of cellular growth (Ishige et al., 2003; Stintzi, 2003; Silberbach and Burkovski, 2006). Moreover, de Carvalho et al. (2010) recently reported antimicrobial activities of ribosomal proteins.
Growth of P. fluorescens Pf0-1 was most strongly reduced when confronted with Bacillus. Apart from the downregulation of ribosomal proteins also other stress-related genes were differentially regulated, such as the prophage genes in the cluster Pfl01_1136 to Pfl01_1173. This prophage region carries two genes annotated as Pyocin R2_PP, holin (Pfl01_1137) and Pyocin R2_PP, lytic enzyme (Pfl01_1172), which may be related to pyocin biosynthesis. Pyocins are proteinaceous, narrow-spectrum antibacterial bacteriocins that are generally effective against closely related species. Whether this prophage region is functional or degenerated in Pf0-1 is not known, but the induction of nearly all genes in this region during the interaction with Bacillus may be an indication of a response to a particular stress factor not encountered by Pf0-1 in the other two interactions. Prophage induction after exposure to DNA-damage-causing agents, oxidative stress, or to other stress factors like antibiotic treatment, heat and starvation has been well documented (Frye et al., 2005; Garcia-Russell et al., 2009), leading to our suggestion that Bacillus induces a specific stress response in Pf0-1.
Organic extracts contained antimicrobial activity when isolated from cultures where P. fluorescens Pf0-1 was interacting with Brevundimonas or Pedobacter, but not Bacillus. The observation that antibiotic production is only triggered during interspecific interactions suggests a cost-effective strategy whereby the antibiotic is produced only when needed, or a strategy to avoid adaptation of competitors to the antibiotic (Garbeva and de Boer, 2009). Evidence that gene clusters Pfl01_3463-66 and Pfl01_3655-59 are indeed involved in the production of an antimicrobial compound was obtained by site-directed mutagenesis followed by activity bioassays. A strain carrying a deletion of these gene clusters did not show antimicrobial activity when confronted with Pedobacter sp. or Brevundimonas sp. In addition, high pressure liquid chromatography analysis confirmed that the mutants Pfl01_Δ3463-66 and Pfl01_3655-59 are defective in the production of compound(s) specifically induced in the wild-type strain when cocultured with Pedobacter or Brevundimonas. The nature and identity of these antimicrobial compound(s) produced by P. fluorescens Pf0-1 are not yet known and will require large-scale extractions, purifications and extensive analytical-chemical analyses (for example, liquid chromatography-mass spectrometry and nuclear magnetic resonance). The observed inhibition of both bacterial and fungal growth suggests that these antimicrobial compound(s) produced by P. fluorescens Pf0-1 can be effective in competitive interactions with many different bacterial and fungal species. It is interesting to note that the antibiotic compound(s) were not produced by P. fluorescens Pf0-1 during confrontation with the Bacillus strain even though growth of Bacillus is affected when exposed to the extracted ccompound(s). This could point to the absence of appropriate cues produced by Bacillus to induce production of the antimicrobial compound(s) by Pf0-1 or to deregulation of its production.
This study did not reveal information on the identity of the cues that trigger the specific differential gene expression observed for P. fluorescens Pf0-1. However, these cues should either be diffusible or volatile metabolites as the differential expression occurred without direct cell–cell contact of P. fluorescens Pf0-1 with the competing strains. In an additional experiment (data not shown), a range of reporter constructs (responding to different N-Acyl Homoserine Lactones, Autoinducer-2 family compounds, or Diffusible Signal Factor compounds) were tested to resolve the putative nature of the signals produced by the interacting bacteria. Brevundimonas sp. was capable of triggering a positive response in a bioreporter strain that detects production of the Diffusible Signal Factor signal 2-dodecenoic acid. P. fluorescens Pf0-1 itself cannot produce Diffusible Signal Factor, but has the gene for perception (Pfl01_3253). Neither Pedobacter sp. nor Bacillus sp. stimulated a response from any of the tested bioreporters (unpublished data). This is again pointing at specificity in the response of P. fluorescens Pf0-1 to different competitors.
In the present work, we studied the response of P. fluorescens Pf0-1 to different bacterial competitors in a one-to-one confrontation. However, in natural environmental settings bacteria are likely to encounter several different competitors at the same time or in sequential events. In such situations, the production of a broad-spectrum antibiotic may be a beneficial strategy for Pf0-1 as it will target diverse competitors. It is even plausible that superior competitors, like Bacillus in the current study, can be inhibited by the antibiotic when it is triggered by another species in a microbial consortium. In this study, we investigated bacteria–bacteria interactions using an agar plate model system. Although these assays are somewhat artificial, they do allow an in-depth analysis of fundamental mechanisms and genes underlying microbial interactions. In addition, the experiments were performed under carbon-limiting conditions, which to some extent mimics the situation in most soils (Demoling et al, 2007; Rousk and Baath, 2007).
It is interesting to note that several of the differentially expressed genes during the inter-specific interactions have an unknown function. Some of these so-called orphan or cryptic genes are commonly found in all three interactions. For example, gene Pfl_1702 encodes a protein of unknown function (DUF989) that is upregulated in all three interactions. A related gene was also previously reported to be upregulated during inter-specific interactions in Pseudomonas sp. A21 (Garbeva and de Boer, 2009). Although our experiments did not reveal the functions nor the products of these genes, they do suggest that these genes have a role in the response to other microbes. It will be interesting in a further study to determine the precise function of such genes in bacterial interactions.
In summary, our results demonstrate that P. fluorescens Pf0-1 shows a species-specific transcriptional and metabolic response to bacterial competitors, which may provide new leads in the identification of specific cues in bacteria–bacteria interactions and of novel competitive strategies, antimicrobial traits and genes.
References
Alden L, Demoling F, Baath E . (2001). Rapid method of determining factors limiting bacterial growth in soil. Appl Environ Microbiol 67: 1830–1838.
Compeau G, Alachi BJ, Platsouka E, Levy SB . (1988). Survival of rifampin-resistant mutants of Pseudomonas fluorescens and pseudomonas putida in soil system. Appl Environ Microbiol 54: 2432–2438.
Curtis TP, Sloan WT, Scannell JW . (2002). Estimating prokaryotic diversity and its limits. Proc Natl Acad Sci USA 99: 10494–10499.
Dantas G, Sommer MOA, Oluwasegun RD, Church GM . (2008). Bacteria subsisting on antibiotics. Science 320: 100–103.
Dasgupta N, Wolfgang MC, Goodman AL, Arora SK, Jyot J, Lory S et al. (2003). A four-tiered transcriptional regulatory circuit controls flagellar biogenesis in Pseudomonas aeruginosa. Mol Microbiol 50: 809–824.
de Boer W, Verheggen P, Gunnewiek P, Kowalchuk GA, van Veen JA . (2003). Microbial community composition affects soil fungistasis. Appl Environ Microbiol 69: 835–844.
de Boer W, Wagenaar AM, Gunnewiek P, van Veen JA . (2007). In vitro suppression of fungi caused by combinations of apparently non-antagonistic soil bacteria. Fems Microbiol Ecol 59: 177–185.
de Carvalho KG, Bambirra FHS, Kruger MF, Barbosa MS, Oloveria JS, Santos AM et al. (2010). Antimicrobial compounds produced by Lactobacillus sakei subsp. sakei 2a, a bacteriocinogenic strain isolated from Brazilian meat product. J Ind Microbiol Biotechnol 37: 381–390.
Demoling F, Figueroa D, Baath E . (2007). Comparison of factors limiting bacterial growth in different soils. Soil Biol Biochem 39: 2485–2495.
Denoya CD . (1995). A second branched-chain alpha-keto acid dehydrogenase gene cluster (bkdFGH) from Sterptomyces avermitilis: its relationship to avermecin biosynthesis and the contruction of a bkdF mutant suitable for production of novel antiparasitic avermectins. J Bacteriol 177: 3504–3511.
Dubuis C, Haas D . (2007). Cross-species GacA-controlled induction of antibiosis in pseudomonads. Appl Environ Microbiol 73: 650–654.
Dubuis C, Keel C, Haas D . (2007). Dialogues of root-colonizing biocontrol pseudomonads. Eur J Plant Pathol 119: 311–328.
Fong KP, Chung WSO, Lamont RJ, Demuth DR . (2001). Intra- and interspecies regulation of gene expression by Actinobacillus actinomycetemcomitans LuxS. Infect Immun 69: 7625–7634.
Frye JG, Porwollik S, Blackmer F, Cheng P, McClelland M . (2005). Host gene expression changes and DNA amplification during temperate phage induction. J Bacteriol 187: 1485–1492.
Gao R, Mack TR, Stock AM . (2007). Bacterial response regulators: versatile regulatory strategies from common domains. Trends Biochem Sci 32: 225–234.
Garbeva P, de Boer W . (2009). Inter-specific interactions between carbon-Limited soil bacteria affect behavior and gene expression. Microb Ecol 58: 36–46.
Garcia-Russell N, Elrod B, Dominguez K . (2009). Stress-induced prophage DNA replication in Salmonella enterica serovar Typhimurium. Infect Genet Evol 9: 889–895.
Harrison F, Paul J, Massey RC, Buckling A . (2008). Interspecific competition and siderophore-mediated cooperation in Pseudomonas aeruginosa. ISME J 2: 49–55.
Heeb S, Haas D . (2001). Regulatory roles of the GacS/GacA two-component system in plant-associated and other gram-negative bacteria. Mol Plant–Microbe Interact 14: 1351–1363.
Horton RM, Hunt HD, Ho SN, Pullen JK, Pease LR . (1989). Engineering hybrid genes without the use of restriction enzymes: gene splicing by overlap extension. Gene 77: 61–68.
Humair B, Wackwitz B, Haas D . (2010). GacA-controlled activation of promoters for small RNA genes in Pseudomonas fluorescens. Appl Environ Microbiol 76: 1497–1506.
Ishige T, Krause M, Bott M, Wendisch VF, Sahm H . (2003). The phosphate starvation stimulon of corynebacterium glutamicum determined by DNA microarray analyses. J Bacteriol 185: 4519–4529.
Martinez JL . (2008). Antibiotics and antibiotic resistance genes in natural environments. Science 321: 365–367.
Martinez JL . (2009). The role of natural environments in the evolution of resistance traits in pathogenic bacteria. Proc R Soc B biol Sci 276: 2521–2530.
Matthews M, Roy CR . (2000). Identification and subcellular localization of the Legionella pneumophila IcmX protein: a factor essential for establishment of a replicative organelle in eukaryotic host cells. Infect Immun 68: 3971–3982.
Raaijmakers JM, Bonsall RE, Weller DM . (1999). Effect of population density of Pseudomonas fluorescens on production of 2,4-diacetylphloroglucinol in the rhizosphere of wheat. Phytopathology 89: 470–475.
Rousk J, Baath E . (2007). Fungal and bacterial growth in soil with plant materials of different C/N ratios. FEMS Microbiol Ecol 62: 258–267.
Ryan RP, Fouhy Y, Garcia BF, Watt SA, Niehaus K, Yang L et al. (2008). Interspecies signalling via the Stenotrophomonas maltophilia diffusible signal factor influences biofilm formation and polymyxin tolerance in Pseudomonas aeruginosa. Mol Microbiol 68: 75–86.
Shank EA, Kolter R . (2009). New developments in microbial interspecies signaling. Curr Opin Microbiol 12: 205–214.
Silberbach M, Burkovski A . (2006). Application of global analysis techniques to Corynebacterium glutamicum: new insights into nitrogen regulation. J Biotechnol 126: 101–110.
Silby MW, Levy SB . (2004). Use of in vivo expression technology to identify genes important in growth and survival of Pseudomonas fluorescens Pf0-1 in soil: discovery of expressed sequences with novel genetic organization. J Bacteriol 186: 7411–7419.
Stintzi A . (2003). Gene expression profile of Campylobacter jejuni in response to growth temperature variation. J Bacteriol 185: 2009–2016.
Stirrett K, Denoya C, Westpheling J . (2009). Branched-chain amino acid catabolism provides precursors for the Type II polyketide antibiotic, actinorhodin, via pathways that are nutrient dependent. J Ind Microbiol Biotechnol 36: 129–137.
Straight PD, Kolter R . (2009). Interspecies chemical communication in bacterial development. Ann Rev Microbiol 63: 99–118.
Strickland MS, Lauber C, Fierer N, Bradford MA . (2009). Testing the functional significance of microbial community composition. Ecology 90: 441–451.
Taga ME, Bassler BL . (2003). Chemical communication among bacteria. Proc Natl Acad Sci USA 100: 14549–14554.
Tai V, Paulsen IT, Phillippy K, Johnson DA, Palenik B . (2009). Whole-genome microarray analyses of Synechococcus-Vibrio interactions. Environ Microbiol 11: 2698–2709.
Torsvik V, Ovreas L . (2002). Microbial diversity and function in soil: from genes to ecosystems. Curr Opin Microbiol 5: 240–245.
Wool IG . (1996). Extraribosomal functions of ribosomal proteins. Trends Biochem Sci 21: 164–165.
Yoon YJ, Kim ES, Hwang YS, Choi CY . (2004). Avermectin: biochemical and molecular basis of its biosynthesis and regulation. Appl Microbiol Biotechnol 63: 626–634.
Acknowledgements
This work is supported by The Netherlands Organization for Scientific Research (NWO). The authors thank Saskia Gerards for her help in extraction of antimicrobial compounds. This is publication No.4568 of the Netherlands Institute of Ecology (NIOO-KNAW).
Author information
Authors and Affiliations
Corresponding author
Additional information
Supplementary Information accompanies the paper on The ISME Journal website
Supplementary information
Rights and permissions
About this article
Cite this article
Garbeva, P., Silby, M., Raaijmakers, J. et al. Transcriptional and antagonistic responses of Pseudomonas fluorescens Pf0-1 to phylogenetically different bacterial competitors. ISME J 5, 973–985 (2011). https://doi.org/10.1038/ismej.2010.196
Received:
Revised:
Accepted:
Published:
Issue Date:
DOI: https://doi.org/10.1038/ismej.2010.196
Keywords
This article is cited by
-
Crop rotation and native microbiome inoculation restore soil capacity to suppress a root disease
Nature Communications (2023)
-
Small changes in rhizosphere microbiome composition predict disease outcomes earlier than pathogen density variations
The ISME Journal (2022)
-
Sequential interspecies interactions affect production of antimicrobial secondary metabolites in Pseudomonas protegens DTU9.1
The ISME Journal (2022)
-
The initial inoculation ratio regulates bacterial coculture interactions and metabolic capacity
The ISME Journal (2021)
-
Rhizobacteria associated with Miscanthus x giganteus improve metal accumulation and plant growth in the flotation tailings
Plant and Soil (2021)